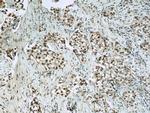
CIRBP Antibody in Immunohistochemistry (Paraffin) (IHC (P))

Search
Proteintech
CIRBP Polyclonal Antibody
{{$productOrderCtrl.translations['antibody.pdp.commerceCard.promotion.promotions']}}
{{$productOrderCtrl.translations['antibody.pdp.commerceCard.promotion.viewpromo']}}
{{$productOrderCtrl.translations['antibody.pdp.commerceCard.promotion.promocode']}}: {{promo.promoCode}} {{promo.promoTitle}} {{promo.promoDescription}}. {{$productOrderCtrl.translations['antibody.pdp.commerceCard.promotion.learnmore']}}
产品信息
10209-2-AP
种属反应
已发表种属
宿主/亚型
分类
类型
抗原
偶联物
形式
浓度
规格
纯化类型
保存液
内含物
保存条件
运输条件
产品详细信息
This antibody (10209-2-AP) is a rabbit polyclonal antibody raised against the full-length CIRBP of human origin.
Immunogen sequence: MASDEGKLF VGGLSFDTNE QSLEQVFSKY GQISEVVVVK DRETQRSRGF GFVTFENIDD AKDAMMAMNG KSVDGRQIRV DQAGKSSDNR SRGYRGGSAG GRGFFRGGRG RGRGFSRGGG DRGYGGNRFE SRSGGYGGSR DYYSSRSQSG GYSDRSSGGS YRDSYDSYAT HNE (1-172 aa encoded by BC000403)
靶标信息
CIRBP is cold-inducible mRNA binding protein that plays a protective role in the genotoxic stress response by stabilizing transcripts of genes involved in cell survival. It acts as a translational activator and seems to play an essential role in cold-induced suppression of cell proliferation. It binds specifically to the 3'-untranslated regions (3'-UTRs) of stress-responsive transcripts RPA2 and TXN. This protein acts as a translational repressor and promotes assembly of stress granules (SGs), when overexpressed.
仅用于科研。不用于诊断过程。未经明确授权不得转售。
生物信息学
蛋白别名: A18 hnRNP; CIRP; cold inducible RNA-binding protein; Cold-inducible RNA-binding protein; glycine-rich RNA binding protein; Glycine-rich RNA-binding protein CIRP; testicular tissue protein Li 39; unnamed protein product
基因别名: A18HNRNP; CIRBP; CIRP; R74941
UniProt ID: (Human) Q14011, (Rat) P60825, (Mouse) P60824
Entrez Gene ID: (Human) 1153, (Rat) 81825, (Mouse) 12696